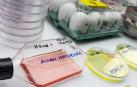
Una muestra del virus de la gripe aviar.

Guadalajara

Sucesos
Mueren dos jóvenes de 25 y 22 años por un nuevo alud en el Pirineo oscense
Uno de los jóvenes fue trasladado con vida al hospital, pero no pudo superar la situación. El segundo falleció en el lugar del suceso

Guadalajara
Alertan de un toro perdido desde hace 5 días tras un festejo
El espectáculo se celebró en la localidad de Romancos, en Guadalajara

Detenida en Guadalajara por sustraer a su hijo y ser sorprendida tratando de comprar drogas en su presencia
Los agentes le dieron el alto y le solicitaron su identificación, a lo que este alegó que la tenía en casa de un familiar y que le podían acompañar hasta allí para verificar su versión. De camino al lugar, emprendió la huida a la carrera con el bebé en brazos

Peralejos de las Truchas (Guadalajara) calienta motores para su tributo a Springsteen
El primer fin de semana de agosto, este pequeño municipio del Alto Tajo de apenas 150 vecinos censados organiza la que ya se ha convertido en su cita del año

San Fermín
Guadalajara promociona en Pamplona sus encierros, que tendrán nuevo recorrido
La ciudad de Castilla-La Mancha busca convertir sus festejos de septiembre en Fiesta de Interés Turístico Nacional

Gimnasia
Un navarro es el mejor gimnasta de España... otra vez
Ander Olcoz se proclama campeón nacional en Primera Categoría arrasando en Guadalajara y su compañero de Lagunak Sergio Osés, es bronce

Guadalajara
Condenado a 15 años de cárcel por matar al ladrón de su coche
El procesado sorprendió al ladrón intentando romper la ventanilla y lo apuñaló

Fallece un joven de 30 años en Guadalajara herido por arma blanca
La Policía Nacional se encuentra investigando lo sucedido, sin que se hayan podido esclarecer aún los hechos, ni se haya llevado a cabo ninguna detención

El Guadalajara se lleva los dos puntos de Anaitasuna
La igualdad fue la nota dominante durante casi todo el encuentro, pero las prisas traicionaron a los pamploneses al final

Anaitasuna pone la mira en dos puntos importantes
“Nos quedan otros 13 partidos y cada uno de ellos va a ser importantísimo y trascendental”, dijo Quique Domínguez sobre el devenir del curso

Operación
Desarticulada una organización criminal que robaba droga a otros traficantes
Como resultado de la operación han sido intervenidos 122 kilogramos de hachís, 32.500 euros y un vehículo de alta gama

Guadalajara 32 - 29 Helvetia
Los errores lastran al Helvetia Anaitasuna en Guadalajara
Tras ir ganando hasta por 5 en la primera mitad (11-16), el equipo navarro no ha aprovechado sus opciones de sentenciar y acaba cayendo en su visita al recién ascendido Guadalajara

Balonmano
Daniel Santamaría, meta del Helvetia Anaitasuna: "En cuanto salto a la pista me transformo, solo pienso en ganar"
El manchego visita este viernes 20 por la noche con Helvetia Anaitasuna al Guadalajara, su club cinco campañas. “Es una experiencia nueva para mí, estoy con muchísimas”, dice el campeón del mundo universitario

Fallece un joven de 20 años tras ser corneado en los encierros de El Casar (Guadalajara)
Fue trasladado al Hospital de La Paz de Madrid, donde falleció en la noche de este sábado

TV
'El Grand Prix del Verano' vuelve a La 1 con Ramón García, el doble de juegos y la participación de San Adrián
Las catorce localidades participantes competirán en siete eliminatorias, dos semifinales y una gran final

El alcalde y la teniente de alcalde (PSOE) de un pueblo de Guadalajara denuncian agresiones
Según han relatado en una rueda de prensa, la más grave fue la agresión que sufrió el 20 de abril el alcalde, que acabó en urgencias tras recibir varios golpes en el rostro y patadas en su cuerpo

Los asesinos de la familia de Chiloeches son amigos del exnovio de la hija
La Guardia Civil cree que decidieron matar a los padres y a la joven al ser sorprendidos 'in fraganti' cuando robaban en la vivienda

La Guardia Civil detiene a varias personas por las tres muertes de Chiloeches
Sus cuerpos, que tenían heridas producidas por armas blancas, fueron encontrados por los bomberos del parque de Azuqueca de Henares

Sociedad
Araceli, la primera mujer que recibió la vacuna contra la covid en España, cumple 100 años
Araceli Hidalgo, que el 27 de diciembre de 2020 recibió la primera vacuna contra la covid-19 en España, se convierte en centenaria

Guadalajara
Detenidos en un túnel excavado para enganchar a la red eléctrica una plantación de marihuana
La plantación, ubicada en el polígono industrial de Canillas del Campo, tenía más de 9.000 plantas de marihuana

Tribunales
El parricida de Brihuega asegura que veía a sus padres "como monstruos"
El acusado aseguró al jurado que no fue consciente del crimen y que actuó bajo el efecto de las drogas

Guardia Civil
Detenido el presunto autor de un incendio en Guadalajara que quemó 3.000 hectáreas en 2022
El detenido, de 38 años, cuenta con numerosos antecedentes policiales por delitos contra el patrimonio

¿Qué santos se celebran hoy? Santoral católico del 15 de junio de 2023
La Iglesia Católica recuerda a la santa que fundó colegios de reeducación para prostitutas

Suceso
Detenida una mujer por la muerte de su pareja en un pueblo de Guadalajara
Al parecer, la mujer asestó a su pareja al menos una puñalada mortal en el transcurso de una discusión

Guadalajara
Bruce Springsteen, la banda sonora de Peralejos de las Truchas
La pasión por el Boss llegó en 1981 a este municipio situado en el Parque Natural del Alto Tajo de la mano de un estudiante que trajo de Madrid sus primeros discos

Himno falangista
Polémica por un edil del PP de Guadalajara grabado cantando el 'Cara al sol'
El presidente del partido en la región, Paco Núñez, ha opinado que a su entender es "una actitud poco ejemplar" que no comparte

Vandalismo
Detenidos 28 grafiteros por realizar pintadas en vagones de trenes en Madrid y Guadalajara
En ocasiones detenían el convoy accionando la palanca del freno de emergencia, generando riesgos para la integridad de los viajeros

Propuestas
Feijóo pide recuperar la deducción por vivienda y que la banca ayude a rentas medias y bajas a pagar la hipoteca
Reclama a Sánchez que se centre en los "problemas" de los españoles y no en hacer un "traje a medida" del independentismo con la sedición

Detienen en Guadalajara a un fugitivo reclamado en Perú como autor de diez asesinatos
El prófugo formaba parte del denominado 'Escuadrón de la Muerte', grupo ilegal de la Policía Nacional de Perú dedicado a ejecutar extrajudicialmente a supuestos delincuentes para ganar ascensos y condecoraciones
Detectan en Guadalajara el primer caso de gripe aviar en humanos de España
Se trata un trabajador de una granja avícola de la provincia de Guadalajara en la que se había producido un foco de gripe aviar

Historia
El códice vuelve al pueblo
Un manuscrito medieval desaparecido en la Guerra Civil regresa a Brihuega (Guadalajara) tras la última voluntad del soldado que se lo llevó para evitar que desapareciera

Suceso
Detenido el hijo del matrimonio asesinado en Guadalajara como presunto autor de los hechos
Será el juez instructor del caso el que determine si ingresa en prisión

Suceso
Hallado un matrimonio muerto con signos de violencia en Guadalajara
Hasta el lugar se han desplazado la Guardia Civil, un médico de Urgencias y una ambulancia de Soporte Vital Básico, que solo han podido certificar la muerte de ambas personas

Historias encadenadas
Vuelo directo de Cádiz a Sangüesa
Pedro Casajús imaginaba una jubilación entre las palomas y la huerta, pero no que llenaría la casa de trofeos. Sus mensajeras coparon el podio de la carrera más larga en España

Guadalajara
Muere una joven y otras ocho personas resultan intoxicadas por monóxido en Azuqueca de Henares
Un grupo electrógeno podría haber provocado la intoxicación

Guadalajara
Un alcalde destinará el presupuesto de las fiestas a sufragar el recibo de electricidad de sus 70 vecinos
La medida beneficiará a quienes están empadronados, apenas 70 vecinos


